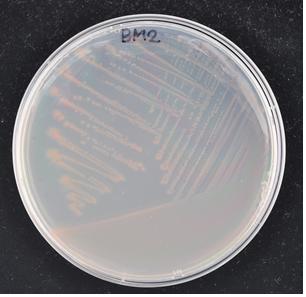

자외선에 강한 신종 세균에서 항염증 효능 찾아 특허 출원
국립생물자원관 이 세균의 항염증 효능을 찾아 특허 출원
홍충선 2016-12-23 10:55:00
[시사인경제]환경부 소속 국립생물자원관은 자외선에 저항력이 높고 항염증 효능이 큰 자생 신종 세균을 찾아 특허 출원 예정이라고 밝혔다.
국립생물자원관, 김명겸 서울여대 교수, 손은화 강원대 교수, 정희영 경북대 교수 등 공동 연구진은 국내 토양에서 세계 최초로 신종 세균인 다이노코커스 액티노스클레루스(Deinococcus actinosclerus) 비엠투(BM2) 균주를 찾고, 이 균주의 세포 추출물에서 항염증 효능을 확인했다.
BM2 균주는 지난해 자생생물 조사·발굴 사업을 통해 전국 각지의 토양을 수집하여 자외선을 쏘아 살아남은 세균을 배양해 발견했으며, 자외선에 대해 대장균의 6배, 사람의 피부세포보다 40배 이상 강한 것으로 나타났다.
연구진은 염증이 유발된 세포에 BM2 균주의 추출물을 처리한 결과, 세포의 염증 물질이 거의 정상수준까지 감소되는 것을 확인했다.
연구진은 인간의 피부는 자외선에 의해 손상되면 염증반응이 일어나지만 자외선에 강한 내성 세균들은 생존을 위해 염증을 억제하는 물질을 가지고 있을 것이라 추측하고 2015년 1월부터 관련 연구를 진행해왔다.
그 결과, 세계 최초로 발견한 이 신종 세균에 대한 정보를 올해 2월 ‘과학기술논문 색인지수’ 논문 중 하나인 국제미생물계통분류학회지(IJSEM, impact factor 2.439)에 게재했다.
또한, BM2 균주의 유전체 염기서열을 해독하여 올해 3월 ‘과학기술논문 색인지수’ 논문 중 하나인 ‘저널 오브 바이오테크놀로지(Journal of Biotechnology, impact factor 2.667)’의 게놈 어나운스먼트(Genome Announcement)에도 발표했다.
연구결과, BM2 균주의 항염 작용 방식은 류머티즘 질환 치료에 처방되는 소염진통제가 염증 물질 생성을 억제하는 방식과 유사하다.
연구진은 BM2 균주의 추출물이 세포독성을 보이지 않아 향후 항염증 치료제의 소재로 활용될 수 있을 것으로 기대하고 있다.
이에 따라, 연구진은 BM2 균주의 추출물에서 항염증 효능이 있는 단일 물질을 규명하고, 이와 관련된 유전자를 파악하기 위한 연구를 진행하고 있다.
백운석 국립생물자원관장은 “새로운 자생 생물자원을 발굴하고 잠재적인 가치를 밝혀내는 일이 국립생물자원관의 가장 큰 임무”라며, “이는 향후 생물자원의 활용가치 증진으로 이어질 수 있다”고 말했다.
|
[시사인경제]환경부 소속 국립생물자원관은 자외선에 저항력이 높고 항염증 효능이 큰 자생 신종 세균을 찾아 특허 출원 예정이라고 밝혔다.
국립생물자원관, 김명겸 서울여대 교수, 손은화 강원대 교수, 정희영 경북대 교수 등 공동 연구진은 국내 토양에서 세계 최초로 신종 세균인 다이노코커스 액티노스클레루스(Deinococcus actinosclerus) 비엠투(BM2) 균주를 찾고, 이 균주의 세포 추출물에서 항염증 효능을 확인했다.
BM2 균주는 지난해 자생생물 조사·발굴 사업을 통해 전국 각지의 토양을 수집하여 자외선을 쏘아 살아남은 세균을 배양해 발견했으며, 자외선에 대해 대장균의 6배, 사람의 피부세포보다 40배 이상 강한 것으로 나타났다.
연구진은 염증이 유발된 세포에 BM2 균주의 추출물을 처리한 결과, 세포의 염증 물질이 거의 정상수준까지 감소되는 것을 확인했다.
연구진은 인간의 피부는 자외선에 의해 손상되면 염증반응이 일어나지만 자외선에 강한 내성 세균들은 생존을 위해 염증을 억제하는 물질을 가지고 있을 것이라 추측하고 2015년 1월부터 관련 연구를 진행해왔다.
그 결과, 세계 최초로 발견한 이 신종 세균에 대한 정보를 올해 2월 ‘과학기술논문 색인지수’ 논문 중 하나인 국제미생물계통분류학회지(IJSEM, impact factor 2.439)에 게재했다.
또한, BM2 균주의 유전체 염기서열을 해독하여 올해 3월 ‘과학기술논문 색인지수’ 논문 중 하나인 ‘저널 오브 바이오테크놀로지(Journal of Biotechnology, impact factor 2.667)’의 게놈 어나운스먼트(Genome Announcement)에도 발표했다.
연구결과, BM2 균주의 항염 작용 방식은 류머티즘 질환 치료에 처방되는 소염진통제가 염증 물질 생성을 억제하는 방식과 유사하다.
연구진은 BM2 균주의 추출물이 세포독성을 보이지 않아 향후 항염증 치료제의 소재로 활용될 수 있을 것으로 기대하고 있다.
이에 따라, 연구진은 BM2 균주의 추출물에서 항염증 효능이 있는 단일 물질을 규명하고, 이와 관련된 유전자를 파악하기 위한 연구를 진행하고 있다.
백운석 국립생물자원관장은 “새로운 자생 생물자원을 발굴하고 잠재적인 가치를 밝혀내는 일이 국립생물자원관의 가장 큰 임무”라며, “이는 향후 생물자원의 활용가치 증진으로 이어질 수 있다”고 말했다.